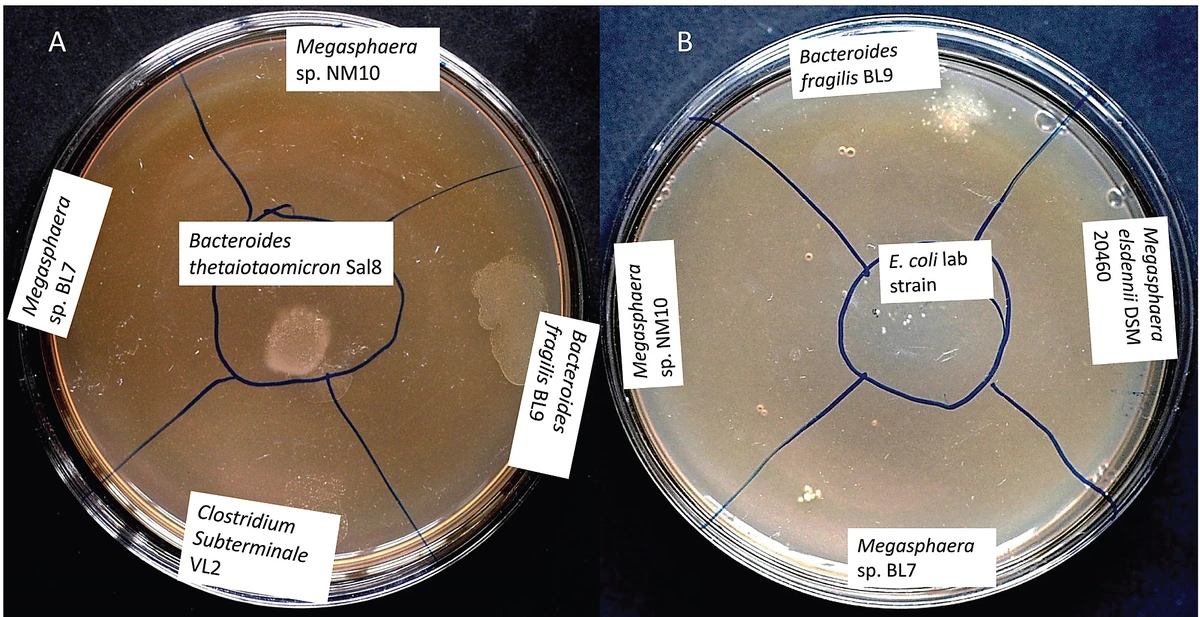

======================================================
Margin requirements play a pivotal role in determining the amount of capital required for trading various financial instruments. Whether you are trading stocks, futures, or cryptocurrencies, understanding how margin works is essential for managing risk, optimizing returns, and ensuring compliance with exchange regulations. In this article, we will perform a comparative analysis of margin requirements, examining how they vary across different markets, trading strategies, and asset classes, with a special focus on perpetual futures. We will also delve into various methods of managing margin efficiently, the risks involved, and best practices for traders at every level.
What Are Margin Requirements?
Margin requirements refer to the minimum amount of capital that a trader must deposit with a broker to open and maintain a trading position. In simple terms, margin acts as a “security deposit” that the trader must maintain in their margin account to ensure they can cover potential losses in the position. The margin requirement is typically expressed as a percentage of the total trade value and varies depending on the asset being traded and the broker’s policies.
Key Types of Margin
- Initial Margin: The amount required to open a position.
- Maintenance Margin: The minimum amount that must be maintained in the margin account to keep the position open.
- Variation Margin: Additional margin that may be required if the market moves against the trader’s position.
Understanding how these margin types work is crucial for managing your capital effectively and avoiding margin calls or forced liquidation.
How Margin Works in Perpetual Futures
Perpetual futures are a popular derivative instrument in markets like cryptocurrencies, offering traders the ability to speculate on price movements without any expiry date. Margin trading in perpetual futures allows traders to leverage their capital and take larger positions than they would be able to with their own funds alone.
How Does Margin Affect Perpetual Futures Trading?
Margin is especially important in perpetual futures because it allows traders to maintain leveraged positions. Leverage amplifies both the potential profits and the risks associated with a trade. A high leverage ratio allows traders to control large positions with a relatively small amount of capital, but it also increases the risk of a margin call if the market moves unfavorably.
The key benefits of margin in perpetual futures include:
- Higher Leverage: Traders can amplify their exposure to price changes without requiring the full value of the contract upfront.
- Increased Flexibility: The ability to trade larger positions with a smaller initial investment offers more flexibility in trading strategies.
- Risk Management Tools: Perpetual futures markets often offer various tools to manage margin, including stop-loss orders and liquidation alerts.
However, margin trading in perpetual futures also carries significant risks. Traders must carefully monitor their margin levels and be prepared for quick changes in market conditions.
Comparative Margin Requirements Across Different Asset Classes
Margin requirements vary not only by asset class but also by the market’s inherent volatility, liquidity, and the regulatory environment. Let’s compare the margin requirements for stocks, futures, and cryptocurrencies to better understand how these instruments differ.
1. Stock Margin Requirements
In traditional stock markets, margin requirements are typically set by regulatory bodies and can vary between brokers. In the United States, for instance, the Federal Reserve sets the initial margin requirement at 50% for most stocks, meaning a trader must deposit at least 50% of the trade value as margin.
- Advantages: Low margin requirements compared to derivatives. Stocks tend to be less volatile than futures and cryptocurrencies, reducing the risk of a margin call.
- Risks: While margin requirements are relatively low, they still expose traders to significant risks, especially during market downturns.
2. Futures Margin Requirements
Futures contracts are standardized agreements to buy or sell an asset at a predetermined price on a specific future date. Margin requirements for futures are generally higher than those for stocks, reflecting the higher risk and volatility involved.
- Initial Margin: Typically ranges from 1-10% of the contract’s total value, depending on the asset being traded (e.g., commodities, indices, or cryptocurrencies).
- Maintenance Margin: Futures contracts often have maintenance margin levels, which can trigger a margin call if the value of the trader’s position falls below the required level.
In perpetual futures, the absence of an expiration date and the ability to carry positions indefinitely often leads to higher margin requirements.
- Advantages: Perpetual futures provide traders with an opportunity to engage in long-term speculation without worrying about contract expiry.
- Risks: The leverage inherent in futures trading means that small price fluctuations can lead to large losses if the trader does not manage their margin carefully.
3. Cryptocurrency Margin Requirements
In cryptocurrency markets, margin trading has become popular due to the high volatility and potential for large gains. However, margin requirements for cryptocurrencies are typically much more flexible and may vary widely depending on the exchange. For example, platforms like Binance and FTX allow leverage of up to 100x on certain pairs, while others offer lower leverage.
- Advantages: High leverage can amplify profits on small price movements, making cryptocurrency margin trading an attractive proposition for experienced traders.
- Risks: Cryptocurrencies are highly volatile, and a small price change can lead to large losses. Given the leveraged nature of margin trading, traders are at high risk of liquidation if they don’t carefully manage their positions.
Managing Margin Risks
Managing margin risk is one of the most important aspects of trading, especially in markets like perpetual futures, where leverage is high. Below are some strategies to help minimize margin risks:
1. Set Stop-Loss Orders
Stop-loss orders are one of the simplest and most effective ways to manage margin risk. A stop-loss automatically triggers a sale of your position if the price reaches a certain level, helping you limit losses.
- Advantages: Reduces the chance of a significant loss if the market moves quickly against your position.
- Risks: In highly volatile markets, stop-loss orders may be triggered too early, potentially locking in losses prematurely.
2. Use a Conservative Leverage Ratio
Leverage amplifies both potential profits and losses, making it crucial to use a conservative leverage ratio. Traders should calculate the maximum leverage they are comfortable with and adjust their margin accordingly to avoid being overexposed.
- Advantages: Limits potential losses and reduces the likelihood of a margin call.
- Risks: Lower leverage reduces potential profits, but this is often a worthwhile trade-off for risk management.
3. Monitor Your Margin Level Regularly
Active monitoring of margin levels is essential for preventing margin calls. By keeping an eye on your positions and margin levels, you can take action before a margin call is triggered.
- Advantages: Helps traders stay on top of market changes and adjust their positions before liquidation occurs.
- Risks: Requires constant attention and can be stressful during high volatility.
Frequently Asked Questions (FAQs)
1. How can I calculate margin requirements for perpetual futures?
To calculate margin requirements for perpetual futures, you need to consider the leverage offered by the exchange and the notional value of the contract. The margin requirement is typically a percentage of the total position size, which varies based on the asset and market conditions.
2. Why are margin requirements higher for cryptocurrency trading?
Margin requirements are higher for cryptocurrency trading due to the inherent volatility of the market. Cryptocurrencies experience sharp price fluctuations, increasing the risk for both the trader and the exchange.
3. What happens if I fail to meet margin requirements in perpetual futures?
If you fail to meet the margin requirements in perpetual futures, the exchange will issue a margin call, requiring you to add more funds to your account. If you do not fulfill the margin call, your position may be liquidated to cover the losses.
Conclusion
Understanding margin requirements is crucial for any trader, particularly those engaging in perpetual futures trading. By comparing margin requirements across asset classes like stocks, futures, and cryptocurrencies, we see that each market has its own set of rules and risk considerations. To be successful in margin trading, traders must carefully monitor their margin levels, use appropriate risk management strategies, and select the right amount of leverage for their trading style. By doing so, they can optimize returns while minimizing the risk of significant losses.